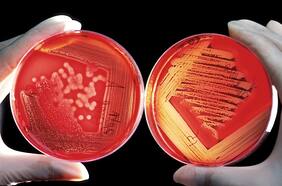

Streptococo
27 MARZO
La alta cantidad de infecciones bacterianas por estreptococo del grupo A encendió las alarmas en Japón, donde está atacando a personas con menos comorbilidades y de manera más rápida. ¿Puede esta bacteria viajar hasta el otro lado del planeta, como lo hizo el coronavirus en la última pandemia?
Aumentan muertes por bacteria carnívora y científicos temen que pueda salirse de control
Lo más leído
3.
4.
5.
Plan digital + LT Beneficios por 3 meses
Comienza el año bien informado y con beneficios para ti ⭐️$3.990/mes SUSCRÍBETE